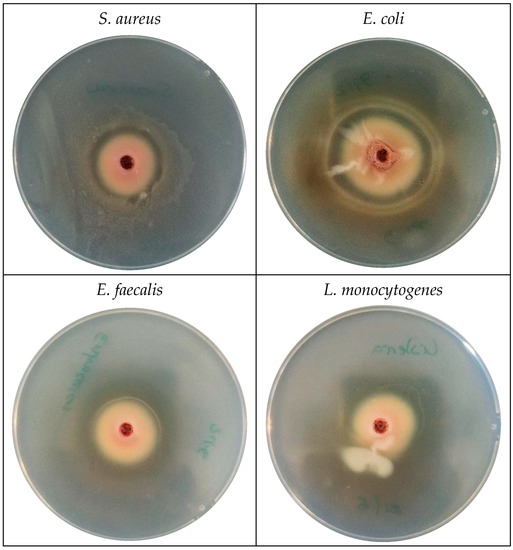

Abstract
The search for new forms to extend foodstuffs’ shelf-life through the use of natural compounds and extracts continues to grow among researchers and the industry. In this line of thought, the main objective of this work was to develop, characterize and evaluate the effectiveness of an active food packaging based on polylactic acid (PLA) and incorporated with natural extracts obtained from grape and/or pomegranate by-products. In vitro, antioxidant methods were applied to evaluate the antioxidant capacity of three extracts: wort extract, freeze-dried pomegranate peels extract (PPE-FD), and natural pomegranate peels (PPE-N). Punicalagin (A + B) and ellagic acid were determined in PPE-FD, PPE-N, and active films by UHPLC-DAD. New PLA-based active packaging with PPE-FD (PLA/3PPE) and pomegranate peels (PLA/3PP) were developed, and their chemical, mechanical, and barrier properties were evaluated. Moreover, the effectiveness of the new film was carried out through the study of lipid oxidation state and microbial contamination of two high-fat content foodstuffs, almonds and beef meat. PPE-FD presented high antioxidant capacity and high content in total phenolics and flavonoid compounds. The PLA/3PPE and PLA/3PP prevented the lipid oxidation of meat and presented antimicrobial activity against Staphylococcus aureus. The addition of the PPE-FD and the pomegranate peels to the PLA did not affect the morphology of the polymer. Although both PPE-FD and pomegranate peels presented punicalagin (A + B) and ellagic acid, only ellagic acid was identified and quantified in the active PLA. Active PLA films were not effective in delaying the lipid oxidation of almonds, but they showed to be significantly effective in delaying the lipid oxidation of beef meat and reducing the microbial growth in this food matrix over time.
1. Introduction
Fruits by-products are often discarded as waste, causing their potential applications to be lost. They are known sources of powerful bioactive compounds with different biological activities involving potential health benefits [1,2]. Phenolic compounds are among these bioactive compounds. They are secondary metabolites formed by plants for their natural defense against pathogenic organisms, predators, parasites, and UV radiation [3,4,5]. Plants’ colors and organoleptic properties can be associated with the presence of certain phenolic compounds, which include flavonoids, catechins, and phenolic acids. The production of these compounds depends on several factors, such as the edaphoclimatic conditions to which the plant was exposed, harvest time, among others, and also, their distribution in the plant is not homogenous, depending on the plant part [3,4,5,6,7].
Pomegranate (Punica granatum L.), native to Asia, is one of the oldest consumed fruits in the world. Only 40% of the fruit is edible (arils), and the rest is constituted by peels (50%) and seeds (10%), making it a major source of by-products. In traditional medicines, it is used for the treatment of vermifuge, asthma, bronchitis, fever, inflammation, and bleeding disorders [1,8]. Its antioxidant and anticancer activities are highly documented in the literature [5,9,10,11,12,13,14,15,16,17]. The most common phenolic compounds present in the pomegranate are ellagitannins, namely punicalagin and ellagic acid [1].
Grapes are one of the most used and consumed fruits in the world, specifically in wine production. According to FAOSTAT, the worldwide grape production in 2020 was 78,034,332 tonnes, and the worldwide wine production in 2019, was 27,025,456 tonnes [18]. Grape by-products resulting from wine production are usually referred to as grape pomace or wort and are rich in catechins, gallic acid, and procyanidins [9,19,20]. All of these compounds are known to possess powerful antioxidant activities. Their distribution in the grape is not homogeneous, being the seeds the part with the highest content in phenolic compounds (60%–70%), followed by skin (28%–35%) and pulp (10%) [1,21].
Food packaging’s main function is to protect foods during transportation and storage, delaying its natural degradation, with no interaction with the packaged food. Active food packaging is a technology that came to revolutionize the concept of food packaging since its main goal is to prolong foods’ shelf-life through the exchange of the package and food. This interaction could be made through the emission of antioxidant or antimicrobial compounds that, by the interaction with the food’s surface, delay or even stop the natural degradation and even improve the organoleptic properties of the packaged food. Previous works describe the incorporation of pomegranate peels and extracts, as well as grape extracts and by-products [22,23,24,25,26,27,28,29].
Lipid oxidation is still one of the main causes for food loss and one of the major enemies of the food industry [30,31,32]. The solution may lie in the gradual emission of active compounds with high antioxidant capacity from the package matrix to the food’s surface, inhibiting the lipid oxidation of highly fatty foods [33,34,35,36,37,38,39].
This work aims to evaluate the antioxidant and antimicrobial potential of natural ethanolic extracts from pomegranate and grape by-products. Moreover, the extracts that showed more promising results in the antioxidant and antimicrobial assays were further incorporated in a polylactic acid (PLA)-based polymeric matrix. Afterwards, the films were characterized in terms of chemical, mechanical and barrier properties. Additionally, the effectiveness of new active films was evaluated through the determination of the lipid oxidation status and microbial contamination of two model foods, almond and beef meat, packaged with these films for different time periods.
2. Materials and Methods
2.1. Reagents and Materials
Absolute ethanol (ACS reagent, for analysis), methanol (ACS reagent (≥99.8%) and for HPLC, ≥99.9%), chloroform (SupraSolv®, for gas chromatography ECD and FID), sodium carbonate anhydrous (ACS reagent), sodium nitrite (ACS reagent), sodium hydroxide (ACS reagent), petroleum ether (ACS reagent, bp 40–60 °C), barium chloride dihydratate (ACS reagent), iron(II) sulfate (pro analysis), iron(III) chloride (anhydrous for synthesis), hydrochloric acid, glacial acetic acid (for HPLC, ≥99.9%), Folin-Cioucalteu’s phenol reagent, were acquired from Merck (Darmstadt, Germany). N-Hexane (SupraSolv®, for gas chromatography ECD and FID) was acquired from Honeywell. Tween®40, β-carotene (≥93%), linoleic acid (analytical standard), gallic acid, 2,5,7,8-tetramethylchromane-2-carboxylic acid (Trolox), epicatechin, aluminum chloride, trichloroacetic acid (ACS reagent, ≥99.0%), 2-thiobarbituric acid (≥98%), 1,1,3,3-tetramethoxypropane (97%), 2,2-diphenyl-1-picrylhydrazyl, xylenol orange sodium (spectrophotometric grade), were acquired from Sigma-Aldrich (Madrid, Spain). Standards punicalagin (A + B) and ellagic acid were acquired from MedChem Express. Ultra-pure water was obtained through a Milli-Q® purification system (Millipore Corp., Belford, NJ, USA).
Also, a compact stirrer Edmund Bühler™ Shaker KS 15 A (Hechingen, Germany), an Eppendorf AG 5804R centrifuge (Hamburg, Germany), a rotary evaporator Büchi model R-210 (Labortechnik, Flawil, Switzerland), a Thermo Scientific Evolution 300 LC spectrophotometer, a RSLAB-6PRO Vortex, Ultra-Turrax IKA® DI 25basic, a Grindomix GM 300 (Retsch) and a Grant Instruments™ QB Series Dry Block Heating System (Cambridge, England) were used.
2.2. Extraction Process
Pomegranate by-products were kindly supplied by Memória Silvestre Lda—Arilo Pomegranates, a Portuguese company dedicated to the production of pomegranates. The peels were manually separated from the seeds. Peels were ground, and a part was freeze-dried. The extraction protocol was applied to the natural and freeze-dried peels.
Wort (in Portuguese, mosto) is the grape by-product after the wine process making. They were retrieved, after the wine production, in Sobreira, Idanha-a-Nova, Portugal, ground and frozen once they arrived at the laboratory.
All the extracts were obtained using absolute ethanol, and the extraction method followed the method described by Andrade et al. [3]. Briefly, the by-products were mixed with ethanol in a 1:10 ratio, homogenized for 30 min at 1000 rpm, and centrifuged for 10 min at 11,952 g. The supernatant was removed into a pear-shaped flask, and the extract was evaporated in the rotary evaporator, until dry, at 35 °C (40 mbar for 45 min). The extract was removed with the aid of a spatula, vacuum packaged, and stored at −20 °C until further use. In total, three ethanolic extracts were produced: wort extract, extract from freeze-dried pomegranate peels (PPE-FD), and extract from natural pomegranate peels (PPE-N).
2.3. Antioxidant Activity and Total Content of Phenolic Compounds and Flavonoids
The in vitro antioxidant activity and the total content of phenolic compounds and flavonoids were performed in the wort, PPE-FD, and PPE-N extracts.
2.3.1. DPPH Radical Scavenging Activity
The applied method was initially described by Moure et al. [40] and modified by Andrade et al. [3]. Briefly, 50 μL of the sample (1 mg/mL) was mixed with 2 mL of a DPPH• methanolic solution (14.2 μg/mL). For the control, 50 μL of ethanol was used instead of the sample. The mixtures were left protected from the light for 30 min. The absorbance was measured at 510 nm in the spectrophotometer. The Inhibition Percentage (IP) of the DPPH• was calculated through Equation (1).
where, Ab stands for the absorbance of the control and As stands for the absorbance of the sample. Also, a calibration curve using Trolox as a standard was drawn, opposing trolox concentration (between 25–175 µg/mL) vs. the inhibition percentage. The equation was y = 0.5303x − 0.5147, with a R2 of 0.9976. The results are expressed in mg trolox equivalents (TE)/g of sample.
2.3.2. Total Content in Phenolic Compounds
The total content in phenolic compounds was performed in accordance with the method described by Erkan et al. [41]. Briefly, 1 mL of the sample was mixed with 7.5 mL of an aqueous Folin-Ciocalteu solution (10%, v/v), homogenized, and left for 5 min. Then, 7.5 mL of an aqueous solution of sodium carbonate (60 mg/mL) was added, and the samples were homogenized and left to stand for 2 h, protected from the light. The absorbance was measured at 725 nm in the spectrophotometer. Using gallic acid as a standard, a calibration curve was drawn opposing the gallic acid concentration (between 10–175 µg/mL) vs. absorbance. The equation was y = 0.0059x − 0.0704, with an R2 of 0.9979. The results are expressed in mg of gallic acid equivalents per g of sample (mg GAE/g).
2.3.3. Total Content of Flavonoids
The total content of flavonoids was measured by applying the method described by Yoo et al. [42]. Succinctly, 1 mL of sample was homogenized with 4 mL of ultrapure water and 300 μL of a sodium nitrite aqueous solution (5%, w/v). The samples were left to stand for 5 min, and 600 μL of aluminum chloride aqueous solution (10%, w/v) was added. The mixture was, once again, homogenized and left to stand for 6 min. Then, 2 mL of sodium hydroxide (1 M, w/v) and 2.1 mL of ultrapure water were added. The mixtures were homogenized, and the absorbance was measured at 510 nm in the spectrophotometer. Using epicatechin as a standard, a calibration curve was drawn opposing the epicatechin concentration (between 5–175 µg/mL) vs. absorbance. The equation was y = 0.0021x + 0.0391, with an R2 of 0.9976, and the results are expressed in mg of epicatechin equivalents per g of sample (mg ECE/g).
2.4. Identification and Quantification of Punicalagin and Ellagic Acid by UHPLC-DAD
The validation, identification, and quantification of punicalagin (A + B) and ellagic acid was performed by Ultra high-performance liquid chromatography (UHPLC) in a UPLC® ACQUITY™ (Waters, Milford, MA, USA) equipped with a DAD detector. To obtain the best separation efficiency, two columns were tested, an ACQUITY™ UPLC® BEH C18 (2.1 mm × 50 mm, 1.7 µm particle size) column and an ACQUITY™ UPLC® RP18 (2.1 mm × 100 mm, 1.7 µm particle size). Also, different column temperatures were tested: 20, 25, 30, and 35 °C.
The best results were achieved with the ACQUITY™ UPLC® BEH C18 column, kept at 35 °C. Samples were kept at 5 °C, and the injection volume was 10 µL. The flow was kept at 0.3 mL/min. Mobile phase A was ultra-pure water acidified with glacial acetic acid at 0.1% (v/v) and mobile phase B was acetonitrile with glacial acetic acid at 0.1% (v/v). The gradient was as follows: 0 min, 95% A; 1 min, 90% A; 2.5 min, 80% A; 3 min, 75% A; 5 min, 90% A.
The method was validated following the parameters: specificity, working range, linearity, Limit of detection (LoD) and Limit of quantification (LoQ), precision (repeatability and intermediate precision), and accuracy (determined by recovery assays of spiked samples of pomegranate by-products).
Mixed solutions containing 300 µg/mL of punicalagin (A + B) and 20 µg/mL of ellagic acid diluted in methanol with 0.1% of glacial acetic acid were made and diluted up to six times. Calibration curves were drawn by plotting the concentration (µg/mL) versus area. Linear range, LoD, and LoQ were determined. Specificity was assessed by comparison of the absorption spectra of the chromatographic peaks between the analytical standards and the samples.
2.5. Incorporation of the Active Compounds into PLA Films
PLA Inzea F18C (Nurel Biopolymers) was used to produce two films with 3 wt.% of the PPE-FD (PLA/3PPE) and another with 3% of the powder from pomegranate peels (PLA/3PP).
Prior to processing, all materials were dried in a convection drying oven at 55 °C for 4 h. Compositions of PLA with pomegranate by-products took place in a twin-screw extruder (Leistritz, Nuremberg, Germany) at an average melt temperature of 170 °C, 150 rpm, a throughput of 5 kg/h, and an average residence time of 1.5 min. The extrudate filaments were air-dried and ground into pellets in a knife mill for subsequent processing.
Prior to blown film extrusion, the pellets were dried in a forced convection oven at 60 °C. The PLA films were prepared using a Periplast single screw extruder L/D = 25. The films were extruded with a screw speed of 50 rpm at a temperature of 170 °C (first heating zone), 175 °C (second zone), and 180 °C (on the remaining). A digital micrometer (No. 293–340, Mitutoyo, Kanagawa, Japan) was used to measure the thickness measurement of the films that was 50 to 60 µm range.
2.6. Films’ Characterization
2.6.1. Fourier Transform Infrared Spectroscopy (FTIR)
To access the structural characterization of the pomegranate by-products and films, Fourier Transformed Infrared Spectroscopy analysis was performed in a 4100 Jasco (Tokyo, Japan) spectrometer in attenuated total reflectance mode (ATR) at 64 scans, 8 cm−1 resolution in a wavelength range of 4000–600 cm−1.
2.6.2. Scanning Electron Microscopy (SEM)
The morphology of the films was assessed by SEM analysis in an FEI Quanta 400 (FEI, Eindhoven, The Netherlands) after fractured in liquid nitrogen and coated with a thin gold-palladium (80/20) film.
2.6.3. Color Measurements
CIELab color space parameters (L*—brightness, a*—red-green and b*—yellow-blue levels) of the control and active films were measured using a Shimadzu UV2401PC reflectance spectrophotometer operating in the range of visible light between 370 to 750 nm with a 2 nm spectral resolution. The total color difference () was determined according to the following formula [43]:
where , and , , and are the parameters of PLA control and produced films with pomegranate by-products, respectively.
The haze of the film samples was measured according to ASTM D1003-00 in a XL-211 Hazegard System. Six specimens were tested for each sample. The total light and diffuse transmittance were measured to calculate haze.
2.6.4. Water Vapor Transmission (WVT)
The WVT of the film was measured according to ASTM E96/E96M-10. Calcium chloride was used as the desiccant, the tests were conducted at 23 ± 2 °C for 16 days, and the samples were weighed every day.
2.6.5. Oxygen Permeability
The film’s oxygen permeability was obtained through the Permeameter DP-100A from Porous Materials, Inc. (Ithaca, NY, USA), with the pressure increase method. Three specimens were collected from the film samples, with a 4 cm diameter. The test was carried out at 23 ± 2 °C with a pressure of 1 atm for 3 h.
2.6.6. Mechanical Properties
The storage modulus and loss factor of the films were assessed by dynamic mechanical analysis (DMA) using a DMA TRITON, with a 10 mm distance between grips, in tensile mode. For this test, samples with a 4 mm width were used, and a load of 1 N was applied at a frequency of 1 Hz in the temperature range of 40 to 130 °C using a heating rate of 2 °C/min. The tensile tests were performed on a mechanical testing machine, INSTRON 5969, with a load cell of 50 kN, at a speed of 100 mm/min, at 23 ± 2 °C, following ASTM D882—02. At least five film specimens, with a length of 160 mm and a width of 25 mm, were used. In both tests, samples were cut in the machine direction (MD).
2.7. Antimicrobial Activity of the Pomegranate Extract
The antimicrobial activity of the PPE-FD was evaluated against Listeria monocytogenes ATCC 13932, Staphylococcus aureus ATCC 25923, Enterococcus faecalis NCTC 775, and Escherichia coli ATCC 25922. First, a Petri dish with Plate Count Agar (PCA) was flooded with the suspension (single/one culture of the inoculum of each microorganism, made from stock cultures isolated in Tryptone Soya agar (TSA)) of each individual microorganism. The excess liquid was removed, and after 10 min, one cavity of 4 mm was made in the PCA, and 65 ± 1 mg of the extract was placed. The plates were incubated at 37 °C in aerobic conditions. The inhibition halo was measured at the end of 24 h.
2.8. Effectiveness of the Active PLA Films
For the antioxidant analysis of the PLA films, an accelerated migration assay was performed according to the method described by López-de-Dicastillo et al. [44], with a few changes. Briefly, circles of 9.08 cm2 of the PLA films were cut and submersed in 10 mL of ethanol 95% (v/v) and kept at 40 °C for 10 days, protected from the light. At the end of this period, the DPPH• inhibition assay (see Section 2.3.1), the total content in phenolic compounds and flavonoids (see Section 2.3.2 and Section 2.3.3), and the content in punicalagin (A + B) and ellagic acid was determined.
Also, in order to total quantify the maximum content of punicalagin (A + B) and ellagic acid, the films were also submerged in 10 mL of methanol and kept protected from the light, at 25 and 40 °C, for 24 h.
For evaluation of the antimicrobial activity of the PLA films, ISO 22196:2011 [45] was followed. The antimicrobial activity of the films was tested against the same microorganisms referred to in Section 2.7. Briefly, a single/one culture of the inoculum of each microorganism, made from stock cultures isolated in Tryptone Soya agar (TSA), was transferred with a 1 µL loop to Brain Hearth Infusion Broth (BHI), the plates were incubated at 37 °C overnight, and the obtained solutions were diluted to 10−4. Squares of 5 cm × 5 cm of each film were placed on a Petri dish, and 0.2 mL from each dilution was applied to each film. To keep the film hydrated, squares of sterile plastic (4 cm × 4 cm) were placed on top of each film. The plates were incubated at 35 °C for 24 h in a humid atmosphere in aerobiosis. At the end of the incubation, 10 mL of Soybean Casein Lecithin Polysorbate (SCDLP) was added to each plate and stirred for 30 s, for neutralizing the antimicrobial agents. From this, serial decimal dilutions (10−1 and 10−2) were performed, and 1 mL was transferred to Petri dishes. Then, 15 mL of PCA at 44–47 °C was added to each dish and carefully mixed by rotating. After complete solidification, the plates were incubated at 35 °C for 48 h in aerobic conditions. At the end of the incubation period, counts of colonies were performed.
2.9. Packaging of the Model Foods
According to the Portuguese National Food Composition Table, the total lipidic content of the almond is 56 g/100 g, of which 4.7 g/100 g are saturated fatty acids, 34.5 g/100 g are monounsaturated fatty acids, and 14.3 g/100 g are polyunsaturated fatty acids, making almond one of the richest foods in unsaturated fatty acids.
Almond was acquired, still in its hard shell, in a local store in Lisbon, Portugal. The hard shell was manually separated with the help of a hammer. Then, to peel the almonds, the edible part was placed in a hot bath (approximately 80 ± 1 °C) for a maximum time of 5 min and manually peeled, ground in a Grindomix, and vacuum packaged with the control PLA and the active PLA (PLA/3PPE and PLA/3PP). The samples were stored at 40 ± 1 °C and at room temperature, protected from the light. The almond sample’s lipid oxidation stored at 40 ± 1 °C was analyzed at the end of 2, 4, 7, 14, 21, and 30 days of storage. The almond sample’s lipid oxidation stored at room temperature was analyzed at 7, 14, and 21 days of storage.
Regarding beef meat, according to the USDA food database, the total lipidic content is 19.07 g/100 g, of which 7.29 g/100 g are saturated fatty acids, 8.48 g/100 g monounsaturated fatty acids, and 0.51 g/100 g are polyunsaturated fatty acids. Pieces of 35 ± 1 g were also vacuum packaged and stored, protected from the light, at 4 °C. The meat oxidation state and microbiological contamination were assessed at the end of 1, 4, 6, 8, and 11 days of storage.
2.10. Lipid Oxidation Evaluation
2.10.1. Thiobarbituric Acid Reactive Substances Assay (TBARS)
The method originally described by Rosmini et al. [46] and adapted by Andrade et al. [33] was performed for the TBARS assay. Briefly, 20 mL of an aqueous solution of trichloroacetic acid (7.5%, w/v) was added to 5 g of sample. The samples were homogenized in a compact stirrer for 1 h at 400–450 rpm. Using a paper filter Whatman No. 1, the samples were filtered, and 2.5 mL of the filtrates were mixed with 2.5 mL of an aqueous solution of 2-thiobarbituric acid (2.88 mg/mL) and kept, at 95 °C, for 30 min. The samples were rapidly cooled with ice for 15 min, and their absorbance was measured at 530 nm in the spectrophotometer against the control (2.5 mL of ultrapure water + 2.5 mL of 2-thiobarbituric acid solution). A calibration curve using 1,1,3,3-tetramethoxypropane was drawn, and the results are expressed in mg of malonaldehyde equivalents per kg of sample (mg MDA/kg).
2.10.2. Fat Extraction
For the determination of the peroxide value and the p-anisidine value, the fat of the samples had to be extracted. Briefly, 10 ± 1 g of sample was mixed with 100 mL of petroleum ether and agitated in the compact stirrer at 350–400 rpm for 1 h. Then, the samples were filtered using a paper filter Whatman No. 4 with 1 g of sodium carbonate anhydrous. The ether was removed using the rotary evaporator at 35 °C.
2.10.3. Peroxide Value Determination
For the peroxide determination, the method described by Shantha & Decker [47] was performed. First, to prepare an iron(II) chloride solution, 50 mL of an aqueous solution of barium chloride (8 mg/mL) was slowly poured under constant stirring in 50 mL of an aqueous solution of iron(II) sulfate. Still under constant stirring, 2 mL of hydrochloric acid (10 N) was added, and the solution was left to stand to allow the deposition of the barium chloride. The supernatant was moved to an amber flask and stored for a maximum time period of 1 week, protected from the light. Then, 50 mg of fat was agitated with the vortex for 2–4 s with 9.8 mL of a chloroform-methanol solution (70%–30%, v/v). Then, 50 μL of a xylenol orange solution (10 mM) was added, the solution was again homogenized in the vortex, and 50 μL of the iron(II) chloride solution was added, the solution was mixed, and, after 5 min, the absorbance was measured at 560 nm in the spectrophotometer. The peroxide value was calculated through Equation (3), and the results are expressed in milliequivalents of oxygen per kilogram of sample (meq O2/kg).
where, As stands for the samples’ absorbance, Ab stands for the blanks’ absorbance, m stands for the slope of the iron(III) calibration curve, m0 stands for the samples’ mass in g, and 55.84 is the atomic weight of iron.
2.10.4. Determination of the p-Anisidine Value
The p-anisidine value determination followed the method described by the British Standard method BS 684-2.24 [48]. Briefly, to 50 mg of fat, 25 mL of n-hexane was added. The solution was placed in the ultrasound for 5 min to make sure that the fat dissolved completely. The absorbance of the solution was measured at 350 nm against n-hexane. Then, to 5 mL of the sample, 1 mL of a p-anisidine in acetic acid (2.5 mg/mL) was added. The samples were placed, for 10 min, in the dark, and their absorbance was measured against the control. The p-anisidine value (AV) was calculated by Equation (4).
where, As stands for the absorbance of the sample at the end of 10 min, AS0 stands for the absorbance of the sample at 0 min, and m is the sample’s weight in g.
2.11. Evaluation of the Microbial Growth in Meat with Active PLA Films
The antimicrobial activity of the active PLA films was evaluated in meat at the end of the same storage days. The total microorganisms count at 30 °C was performed using the automated method TEMPO® Aerobic Count-AFNOR BIO 12/35–05/13.
2.12. Statistical Analyses
All the assays were performed in triplicate. The results are expressed in mean ± standard deviation. The statistical analysis was performed using the software IBM® SPSS® Statistics, version 27.0.1.0 (Chicago, IL, USA), using a one-way analysis of variance (ANOVA) and ANOVA with repeated measures. The differences among mean values were processed by the Tukey test.
3. Results
3.1. Extracts’ Antioxidant Capacity and Total Content of Phenolic Compounds and Flavonoids
The antioxidant capacity of the extracts is compiled in Table 1. PPE-FD presented the highest inhibition percentage (175.3 ± 0.38 mg TE/g) and content of total phenolic compounds (221.5 ± 0.62 mg GAE/g) and total flavonoids (31.39 ± 0.61 mg ECE/g). The extract obtained from wort presented a low inhibition percentage and a low content of phenolic compounds. Also, the wort extract’s total content in flavonoids was not possible to be determined since the solution kept precipitating.

Table 1.
Antioxidant capacity of the extracts.
Based on the results from Table 1, associated with the difficulty in obtaining a workable extract from the wort, PPE-FD was chosen to be incorporated into the PLA active packaging.
Comparing these results with the literature and a recent review paper by Andrade et al. [1], PPE-FD presented, in general, higher antioxidant capacity and total content of phenolic compounds. The DPPH radical inhibition percentage is similar to the inhibition percentage reported by Rashid et al. [49] (97.3%) in the pomegranate extract obtained with ultrasonic-assisted extraction with ethanol 70% (v/v). However, in the other pomegranate extract obtained through maceration by the same authors, the inhibition percentage is much lower (48.7%). Lower inhibition DPPH radical percentages were also found in the hydroethanolic extract by Selahvarzi et al. [50] (72.11%). El-Hadary and Taha [51] found similar inhibition percentages in pomegranate peel extract obtained with methanol 80% (v/v).
The phenolics content of both pomegranate extracts was higher than the results reported by Zago et al. [52], Rashid et al. [49], and by Selahvarzi et al. [50] (66.14 mg GAE/g; 37. 52 mg GAE/g and 2.70 mg GAE/g, respectively). However, higher content of phenolic compounds was reported by Rashid et al. [49] (277.6 mg GAE/g) in a pomegranate extract obtained with ethanol 70% (v/v) by ultrasonic-assisted extraction. Other solvents, such as methanol and acetone, can be more efficient in extracting bioactive compounds than ethanol. However, these may raise safety concerns [53].
3.2. Films’ Characterization
3.2.1. FTIR & SEM
As can be seen in Figure 1, the PLA spectrum matches the PLA spectrum presented by Yuniarto et al. [54] and Bodbodak et al. [55]. The incorporation of the PPE-FD and the pomegranate peels (PP) seemed to have no effect on the PLA structure. Bodbodak et al. [55] only reported a slight shift in the C–OH and carbonyl groups, at 1750–1754 cm−1, with the addition of the pomegranate peel extract, which was not observed in this study. Also, Miletićet al. [56] and Dai et al. [57] also reported no changes in PLA-based nanofibers with pomegranate seed oil and PLA active films with pomegranate peel extract, respectively. The change in 1716 cm−1 peak intensity for both PLA/3PPE and PLA/3PP confirms the presence of pomegranate by-products in the film samples.

Figure 1.
FTIR spectrum of the pomegranate extract (PPE-FD), control (PLA), and active films (PLA/3PPE and PLA/3PP).
Observing the SEM images in Figure 2, for the control and active PLA films, a clear distinction can be seen among the control PLA, the PLA/3PPE, and PLA/3PP. The PLA scanning shows similar results to previous studies [57]. PLA/3PPE presents a more homogenized distribution than PLA/3PP, which presents layers indicating a non-homogenous distribution of the pomegranate peel. Also, the roughness of the PLA/3PP surface is more pronounced due to the presence of larger pomegranate peel particles embedded in the PLA matrix.

Figure 2.
Photographs of the control (PLA) and the active (PLA/3PPE and PLA/3PP) films and the respective SEM images.
3.2.2. Water Vapor and Oxygen Permeability and Color Measurements
In terms of the films’ color parameters (Table 2), PLA/3PPE presented a higher variation in terms of L*, a*, and b* when compared to the PLA than the PLA/3PP. The film that came closest to the color of the standard film (neat PLA) was PLA/3PP, as can be seen by the coordinates ΔL*, Δa*, and Δb*. The L* parameter (lightness) showed low values for all the samples, with PLA/3PPE having the lowest value of 40.84. The a* parameter, related to the green-red axis, showed a slight increase with the incorporation of pomegranate extract, contrary to the incorporation of pomegranate peel which maintained this parameter compared to the standard sample. The b* parameter, related to the blue-yellow axis, showed an increase from 4.65 to 8.77 with the incorporation of pomegranate extract, whereas the incorporation of pomegranate peels only increased to 6.485. These differences in the values of the Cielab coordinates do not significantly change the color of these films. The Cielab coordinates indicate that the films have a grayer color, although they visibly have a more brownish color. Overall, the change in color is more pronounced for the PLA/3PPE sample due to an even distribution of the additive compared to PLA/3PP.

Table 2.
Optical properties of the control (PLA) and active (PLA/3PPE and PLA/3PP) films.
PLA Haze, 17.5 ± 0.2%, slightly increased with the incorporation of pomegranate extract, 19.0 ± 0.1%, and pomegranate peel, 19.2 ± 0.4%.
Regarding barrier properties, the WVT tests were only performed for PLA and PLA/3PPE. The PLA film presented a WVT of 1.99 ± 0.57 g/m2h having the film of PLA/3PPE obtained a very similar result of 1.94 ± 0.64 g/m2h. The incorporation of pomegranate extract did not alter the water vapor barrier properties of the PLA film.
3.2.3. Mechanical Properties
The tensile test results can be seen in Figure 3 in MD. The sample with the highest modulus and strength was the neat PLA. The values of the tensile test results relative to the other samples are much lower except for the percentage of deformation at the break, which increased considerably for the PLA/3PPE sample. It seems that the introduction of low-mass molecules acts as a slip agent, allowing the polymer molecules to move, which increases the plastic region of the material. The incorporation of both pomegranate extract and peel clearly translates into a loss in stiffness.

Figure 3.
Representative stress vs. strain curves of PLA, PLA/3PPE, and PLA/3PP in MD (a) and respective mechanical indexes (b–e).
Through dynamic mechanical analysis (Figure 4), it is possible to observe that both pomegranate extract and peel have distinct effects on the polymeric matrix. DMA results show a well-defined peak around 57 °C, which is related to the molecular relaxation of PLA chains (Tg). The presence of large particles (PLA/3PP) shifts the peak to a higher temperature (60 °C), indicating that the peel particles restrict molecular mobility. On the other hand, pomegranate extract only increases the value of tan δ, showing that PLA/3PPE has a higher loss module than PLA itself. These results are in agreement with tensile tests, where pomegranate extract has a positive effect on PLA ductile behavior, allowing PLA molecules to move more freely. Also, pomegranate by-products lower the storage modulus (E’) over the temperature range, decreasing the stiffness of the polymer matrix.

Figure 4.
DMA curves of PLA, PLA/3PPE, and PLA/3PP in MD direction: tan δ (a) and storage (E′) and loss (E″) modulus (b).
3.3. Antioxidant Capacity of the PLA Films
The antioxidant capacity and the total content of phenolic compounds and flavonoids of the active PLA can be observed in Table 3. PLA/3PPE significantly presented a higher inhibition percentage and a higher content in total phenolic compounds than the PLA/3PP. PLA/3PP presented a significantly higher content of flavonoids.

Table 3.
Antioxidant capacity and total content of phenolic compounds and flavonoids of the active PLA films.
Bodbodak et al. [55] developed active nanofiber based in PLA with a pomegranate peel extract by electrospinning that showed a DPPH radical inhibition percentage between 50 and 60% in the nanofibers with 5 and 10% of the extract. The inhibition percentages reported by these authors were higher than those reported in the present study, but the applied methodology for the migration assay did not follow the same procedure. Miletić et al. [56] also reported higher antioxidant activities of PLA-based nanofibers with 5 and 10% of pomegranate seed oil (43.53 and 40.94%, respectively). Dai et al. [57] also reported high antioxidant activity in PLA-based films with pomegranate peel extract. PLA is a hydrophobic polymer. The introduction of polar and hydrophilic groups, such as pomegranate peels, may lead to the decrease of the PLA contact angle and, consequently, promote its hydrophilicity [55,58]. Concerning active food packaging, PLA’s hydrophobicity is considered a limitation due to its low ability to encapsulate and gradually release antimicrobial and/or antioxidant compounds [55]. The higher release of phenolic compounds in the PLA/3PPE (Table 3) suggests that the pomegranate peels have higher compatibility with PLA than the PPE-FD.
3.4. Identification and Quantification of Punicalagin (A + B) and Ellagic Acid by UHPLC-DAD
The chromatographic parameters of the method to identify and quantify punicalagin (A + B) and ellagic acid can be observed in Table 4. Also, Table 5 presents the content in punicalagin (A + B) and ellagic acid of the PPE-FD, freeze-dried pomegranate peels, pomegranate peels, and active films (PLA/3PPE and PLA/3PP).

Table 4.
Validation parameters of the UHPLC-DAD method for the identification and quantification of punicalagin (A + B) and ellagic acid in the pomegranate extracts and in the active films.

Table 5.
Quantification of punicalagin (A + B) and ellagic acid in the pomegranate extract, pomegranate peels, and active films.
Punicalagin is one of the major phenolic compounds present in the pomegranate peels and mesocarp, with reported anti-inflammatory, antioxidant and antimicrobial activities [53,59]. Being a water-soluble compound, punicalagin can be spontaneously hydrolyzed into ellagic acid [53]. Ellagic acid is known for its antioxidant, antimutagenic, and anticancer activities [60,61].
PPE-FD presented the highest content in punicalagin and ellagic acid, followed by the freeze-dried PP. El-Hadary and Taha [51] found lower content of ellagic acid (125.61 mg/kg) in pomegranate peel extract obtained with methanol 80%. The authors did not quantify the punicalagin (A + B).
Comparing the results found in the active PLA films, both PLA/3PPE and PLA/3PP presented similar content in ellagic acid. Punicalagin was not found in the food simulant for fatty foods (ethanol 95%, v/v) nor in methanol; this might be due to the high molecular weight of punicalagin (1 084.71 g/mol) [53], which prevents the migration of the molecule to the food simulant/solvent (punicalagin might be entrapped in the polymeric matrix) or due to the hydrolyzation of punicalagin into ellagic acid. Significant differences in the extraction of ellagic acid can be observed between the ethanol (95%) and methanol extraction. Methanol, although it is not an approved solvent extraction for migration assays by the European Union, it is clear that this solvent can significantly extract more ellagic acid from PLA-based films than the appointed solvent for fatty foods [62]. Also, temperature plays a significant role in the extraction of these compounds in PLA-based packaging.
3.5. Antimicrobial Activity of the Extract and the Active PLA Films
Regarding the antimicrobial activity of the extract, the results can be observed in Figure 5. Inhibition hallows can be observed for S. aureus (40 mm in diameter), E. coli (30 mm in diameter), and Enterococcus spp. (12 mm in diameter). No inhibition was observed against L. monocytogenes.
Figure 5.
Antimicrobial activity of the pomegranate extract.
Antimicrobial activity against S. aureus and E. coli of extracts obtained from pomegranate peels is reported in the literature [26,63,64,65]. Three of these studies also reported the antimicrobial activity of pomegranate peel extracts against L. monocytogenes, which was not observed in this study. The main differences between the pomegranate extract from the present work and the other extracts are the extraction processes. Although the extract developed by Harini et al. [53], using 100% ethanol as solvent was similar to the extraction procedure, the ratio between the pomegranate peels and the solvent is different, as well as the extraction time (30 min for 16 h). The other pomegranate extracts were obtained with different solvents and different temperatures. These differences can explain the lack of antimicrobial activity against L. monocytogenes.
The results obtained for the antimicrobial activity of active PLA can be observed in Table 6. The PLA/3PPE and PLA/3PP presented antimicrobial activity against S. aureus. Also, a decrease in the count of bacteria in the L. monocytogenes with PLA/3PPE seems to indicate a potential antimicrobial activity against this microorganism. However, neither the PLA/3PPE nor the PLA/3PP presented antimicrobial activity against E. coli and E. faecalis.

Table 6.
Antimicrobial activity of the control (PLA) and active (PLA/3PPE and PLA/3PP) films.
Bodbodak et al. [55] and Dai et al. [57] reported antimicrobial activity of nanofibers and active films with pomegranate peel extracts against S. aureus and E. coli. Mushtaq et al. also reported antimicrobial activity of an aqueous pomegranate peel extract against not only E. coli and S. aureus but also Proteus vulgaris, Microcoocus luteus, and E. faecalis.
3.6. Lipid Oxidation of the Almond Packaged with the Active Films
The MDA eq. values (Table 7 and Table 8) of the almond packaged with the PLA significantly increased over time. A significant rise of the MDA eq. value occurs until the 4th day of accelerated storage in the almonds packaged with the PLA, PLA/3PPE, and PLA/3PP. Then, on the 4th day of accelerated storage, the almonds packaged with the PLA/3PP presented a significantly higher MDA eq. value than the almonds packaged with the PLA. On the 21st day of storage, the PLA/3PPE presented a significantly lower MDA eq. value than the PLA and PLA/3PP. On the 30th day of accelerated storage, only the PLA/3PP showed significantly higher MDA eq. values than the PLA and PLA/3PPE. Looking at the TBARS results from the almonds stored at room temperature, no significant differences can be observed between the three types of packaging. However, the MDA eq. value significantly increased in the almonds packaged with the PLA/3PP.

Table 7.
Results of the TBARS assay, determination of the peroxide value, and the p-anisidine value of the almonds packaged with control and active PLA, stored at 40 °C (accelerated assay).

Table 8.
Results of the TBARS assay, determination of the peroxide value, and the p-anisidine value of the almonds packaged with control and active PLA, stored at room temperature (23 °C).
In the peroxide assay results (Table 7 and Table 8), there are no significant differences in the almonds packaged with the PLA over time, either in the accelerated assay or in the assay at room temperature. However, in the accelerated assay, the active films presented significantly lower peroxide values than the control on the 7th storage day. In the almonds stored at room temperature, there are no significant differences between the control PLA and the PLA/3PPE and PLA/3PP.
In the accelerated assay, the PLA/3PPE and the PLA/3PP showed lower p-anisidine values than the PLA at the end of 2 storage days. Also, the PLA/3PP showed significantly lower p-anisidine values at the end of 21 storage days. In the almond stored at room temperature, PLA/3PP showed a lower p-anisidine value than the PLA at the end of the 7th day of storage.
The results seem to indicate that the PLA/3PP is more efficient in preventing lipid oxidation than the PLA/3PPE. However, in the three lipid oxidation assays, both films accelerated the lipid oxidation process instead of delaying it, with the exception of the 7th day of storage in the assay at room temperature and on the 21st day of storage. These results indicate that this type of packaging is not indicated to store almonds for long time periods since they cannot prevent the formation of primary and secondary lipid oxidation products.
Nevertheless, the in vivo antioxidant potential of pomegranate extracts is reported in the scientific literature. For example, El-Hadary and Taha [51] applied pomegranate peel extract to sunflower, soybean, and corn oil and submitted the oils to 70 °C for 10 days. The pomegranate peel extract, when compared to the control, significantly decreased the peroxide value content and the p-anisidine value of the oils in the 10-day period.
3.7. Lipid Oxidation and Antimicrobial Analysis of the Meat Packaged with Active Films
Regarding the lipid oxidation of the meat packaged with the PLA films (Figure 6), both active PLA films were significantly effective in delaying meats’ lipid oxidation in comparison to PLA. Between the two active films, PLA/3PP was more effective than PLA/3PPE. Contrary to the results obtained in the almond assays, a clear decrease can be observed in the malonaldehyde equivalents over time.

Figure 6.
Results of the TBARS assay of the beef meat packaged with the control (PLA) and the active (PLA/3PPE and PLA/3PP) films. The uppercase letters compare the same packaging for different storage days. Different letters, for either lowercase/uppercase comparison, represent results with significant differences.
The results from the total microorganism count of the meat can be observed in Table 9. The meat packaged with the PLA showed significant growth of microorganisms on the 4th storage day and again on the 11th storage day, as opposed to the meat packaged with the active PLA (PLA/3PPE and PLA/3PP). The microbiological growth in the meat packaged with the PLA presented a significant growth on the 4th and 8th storage days. The same was not observed in the meat packaged with the active PLA, indicating that the active PLA-based films possess some antimicrobial activity. The microbiological assay results support the hypothesis that both PE and PP are viable additives to be applied to meat and meat products to delay lipid oxidation and to assure meat and meat products’ safety.

Table 9.
Results of the total microorganism count regarding the meat packaged with the control (PLA) and the active (PLA/3PPE and PLA/3PP) films.
The results of the present study are in agreement with the scientific literature since the antimicrobial activity of the pomegranate by-products and its extracts are reported against both Gram-positive and Gram-negative bacteria [66,67,68,69].
4. Conclusions
A pomegranate peel extract with high antioxidant capacity and high content of total phenolic compounds and flavonoids was successfully obtained with a simple and economical solvent-extraction method, using only ethanol (a food-grade solvent) as an extraction solvent. On the other hand, the ethanolic extract obtained from wort did not present high antioxidant activity. A chromatographic method for the identification and quantification of punicalagin (A + B) and ellagic acid was successfully validated by the UHPLC-DAD system. The components were quantified in the pomegranate peel, natural and freeze-dried, and in the pomegranate extract.
Pomegranate extract (PE) and pomegranate peel (PP) were successfully incorporated into active polylactic acid-based packages (PLA/3PPE and PLA/3PP). The addition of the PE and the PP seemed to have no significant interference with the morphologic characteristics of the PLA. It was only possible to quantify ellagic acid in the active films both in the food simulant (ethanol 95%, v/v) and extraction solvent (methanol). PE presented antimicrobial activity against strains of S. aureus, E. coli, and E. faecalis, but the active films only presented antimicrobial activity against S. aureus, suggesting that the PLA traps the antimicrobial compounds.
Regarding lipid oxidation, the active films were extremely efficient in protecting the beef meat against lipid oxidation and microbiological growth when compared to the control PLA. The same cannot be concluded in the almond assays, indicating that this new active packaging is more suitable for extending the shelf life of meat and meat products.
Author Contributions
Conceptualization, M.A.A., A.V.M. and A.S.S.; methodology, M.A.A., P.V.R., C.B., V.C., C.H.B., A.C. and R.F.; software, M.A.A., P.V.R. and C.B.; validation, A.V.M., C.B.C., M.S., F.V., A.S.S. and F.R.; formal analysis, M.A.A., A.V.M., and A.S.S.; investigation, M.A.A.; resources, A.V.M., A.S.S., M.S. and F.R.; data curation, M.A.A., P.V.R., C.B. and V.C.; writing—original draft preparation, M.A.A., P.V.R., C.B. and V.C.; writing—review and editing, A.V.M., C.H.B., C.B.C., M.S., F.V., F.R. and A.S.S.; visualization, A.V.M., F.R. and A.S.S.; supervision, A.V.M., F.R. and A.S.S.; project administration, A.S.S. and F.R.; funding acquisition, A.S.S. and F.R. All authors have read and agreed to the published version of the manuscript.
Funding
This paper was carried out under the MobFOOD Project (POCI-01-0247-FEDER-024524 and LISBOA-01-0247-FEDER-024524), funded by POCI (Operational Programme “Competitiveness and Internationalization”) and POR Lisboa (Lisbon Regional Operational Programme), through ANI, and by the Programa de Cooperación Interreg-A España–Portugal (POCTEP) 2014–2020 (project 0377_IBERPHENOL_6_E). This research was also funded by PT national funds (FCT/MCTES, Fundação para a Ciência e Tecnologia and Ministério da Ciência, Tecnologia e Ensino Superior) through the grant UIDB/00211/2020.
Institutional Review Board Statement
Not applicable.
Informed Consent Statement
Not applicable.
Data Availability Statement
Not applicable.
Acknowledgments
Cássia H. Barbosa is grateful for her Ph.D. Grant 2021.08154.BD is funded by Foundation for Science and Technology (FCT), Portugal. The authors also would like to thank Talho Girassol, LDA, for kindly supplying the beef meat samples and Sidney Tomé for his contribution to the statistical analysis.
Conflicts of Interest
The authors declare no conflict of interest.
References
- Andrade, M.A.; Lima, V.; Sanches Silva, A.; Vilarinho, F.; Castilho, M.C.; Khwaldia, K.; Ramos, F. Pomegranate and grape by-products and their active compounds: Are they a valuable source for food applications? Trends Food Sci. Technol. 2019, 86, 68–84. [Google Scholar] [CrossRef]
- Martínez, R.; Torres, P.; Meneses, M.A.; Figueroa, J.G.; Pérez-Álvarez, J.A.; Viuda-Martos, M. Chemical, technological and in vitro antioxidant properties of mango, guava, pineapple and passion fruit dietary fibre concentrate. Food Chem. 2012, 135, 1520–1526. [Google Scholar] [CrossRef] [PubMed]
- Andrade, M.A.; Ribeiro-Santos, R.; Costa Bonito, M.C.; Saraiva, M.; Sanches-Silva, A. Characterization of rosemary and thyme extracts for incorporation into a whey protein based film. LWT-Food Sci. Technol. 2018, 92, 497–508. [Google Scholar] [CrossRef]
- Hill, L.E.; Gomes, C.; Taylor, T.M. Characterization of beta-cyclodextrin inclusion complexes containing essential oils (trans-cinnamaldehyde, eugenol, cinnamon bark, and clove bud extracts) for antimicrobial delivery applications. LWT-Food Sci. Technol. 2013, 51, 86–93. [Google Scholar] [CrossRef]
- Dai, J.; Mumper, R.J. Plant Phenolics: Extraction, Analysis and Their Antioxidant and Anticancer Properties. Molecules 2010, 15, 7313–7352. [Google Scholar] [CrossRef]
- Almela, L.; Sánchez-Muñoz, B.; Fernández-López, J.A.; Roca, M.J.; Rabe, V. Liquid chromatograpic–mass spectrometric analysis of phenolics and free radical scavenging activity of rosemary extract from different raw material. J. Chromatogr. A 2006, 1120, 221–229. [Google Scholar] [CrossRef]
- Dvaranauskaite, A.; Venskutonis, P.; Raynaud, C.; Talou, T.; Viškelis, P.; Sasnauskas, A. Variations in the essential oil composition in buds of six blackcurrant (Ribes nigrum L.) cultivars at various development phases. Food Chem. 2009, 114, 671–679. [Google Scholar] [CrossRef]
- Reddy, M.; Gupta, S.; Jacob, M.; Khan, S.; Ferreira, D. Antioxidant, Antimalarial and Antimicrobial Activities of Tannin-Rich Fractions, Ellagitannins and Phenolic Acids from Punica granatum L. Planta Med. 2007, 73, 461–467. [Google Scholar] [CrossRef]
- Özalp Özen, B.; Soyer, A. Effect of plant extracts on lipid and protein oxidation of mackerel (Scomber scombrus) mince during frozen storage. J. Food Sci. Technol. 2018, 55, 120–127. [Google Scholar] [CrossRef]
- Kim, N.D.; Mehta, R.; Yu, W.; Neeman, I.; Livney, T.; Amichay, A.; Poirier, D.; Nicholls, P.; Kirby, A.; Jiang, W.; et al. Chemopreventive and adjuvant therapeutic potential of pomegranate (Punica granatum) for human breast cancer. Breast Cancer Res. Treat. 2002, 71, 203–217. [Google Scholar] [CrossRef]
- Deng, Y.; Li, Y.; Yang, F.; Zeng, A.; Yang, S.; Luo, Y.; Zhang, Y.; Xie, Y.; Ye, T.; Xia, Y.; et al. The extract from Punica granatum (Pomegranate) peel induces apoptosis and impairs metastasis in prostate cancer cells. Biomed. Pharmacother. 2017, 93, 976–984. [Google Scholar] [CrossRef] [PubMed]
- Shirode, A.B.; Kovvuru, P.; Chittur, S.V.; Henning, S.M.; Heber, D.; Reliene, R. Antiproliferative effects of pomegranate extract in MCF-7 breast cancer cells are associated with reduced DNA repair gene expression and induction of double strand breaks. Mol. Carcinog. 2014, 53, 458–470. [Google Scholar] [CrossRef] [PubMed]
- Pantuck, A.J.; Leppert, J.T.; Zomorodian, N.; Aronson, W.; Hong, J.; Barnard, R.J.; Seeram, N.; Liker, H.; Wang, H.; Elashoff, R.; et al. Phase II Study of Pomegranate Juice for Men with Rising Prostate-Specific Antigen following Surgery or Radiation for Prostate Cancer. Clin. Cancer Res. 2006, 12, 4018–4026. [Google Scholar] [CrossRef] [PubMed]
- Rettig, M.B.; Heber, D.; An, J.; Seeram, N.P.; Rao, J.Y.; Liu, H.; Klatte, T.; Belldegrun, A.; Moro, A.; Henning, S.M.; et al. Pomegranate extract inhibits androgen-independent prostate cancer growth through a nuclear factor-B-dependent mechanism. Mol. Cancer Ther. 2008, 7, 2662–2671. [Google Scholar] [CrossRef]
- Seeram, N.P.; Aronson, W.J.; Zhang, Y.; Henning, S.M.; Moro, A.; Lee, R.; Sartippour, M.; Harris, D.M.; Rettig, M.; Suchard, M.A.; et al. Pomegranate Ellagitannin-Derived Metabolites Inhibit Prostate Cancer Growth and Localize to the Mouse Prostate Gland. J. Agric. Food Chem. 2007, 55, 7732–7737. [Google Scholar] [CrossRef]
- Kasimsetty, S.G.; Bialonska, D.; Reddy, M.K.; Ma, G.; Khan, S.I.; Ferreira, D.; Blalonska, D.; Reddy, M.K.; Ma, G.; Khan, S.I.; et al. Colon cancer chemopreventive activities of pomegranate ellagitannins and Urolithins. J. Agric. Food Chem. 2010, 58, 2180–2187. [Google Scholar] [CrossRef]
- Nuñez-Sánchez, M.A.; Dávalos, A.; González-Sarrías, A.; Casas-Agustench, P.; Visioli, F.; Monedero-Saiz, T.; García-Talavera, N.V.; Gómez-Sánchez, M.B.; Sánchez-Álvarez, C.; García-Albert, A.M.; et al. MicroRNAs expression in normal and malignant colon tissues as biomarkers of colorectal cancer and in response to pomegranate extracts consumption: Critical issues to discern between modulatory effects and potential artefacts. Mol. Nutr. Food Res. 2015, 59, 1973–1986. [Google Scholar] [CrossRef]
- Food and Agriculture Organization of the United Nations (FAO) FAOSTAT. Available online: https://www.fao.org/faostat/en/#data/QCL (accessed on 1 April 2022).
- de Campos, L.M.A.S.; Leimann, F.V.; Pedrosa, R.C.; Ferreira, S.R.S. Free radical scavenging of grape pomace extracts from Cabernet sauvingnon (Vitis vinifera). Bioresour. Technol. 2008, 99, 8413–8420. [Google Scholar] [CrossRef]
- Maier, T.; Schieber, A.; Kammerer, D.R.; Carle, R. Residues of grape (Vitis vinifera L.) seed oil production as a valuable source of phenolic antioxidants. Food Chem. 2009, 112, 551–559. [Google Scholar] [CrossRef]
- Ribeiro-Santos, R.; Carvalho-Costa, D.; Cavaleiro, C.; Costa, H.S.; Albuquerque, T.G.; Castilho, M.C.; Ramos, F.; Melo, N.R.; Sanches-Silva, A. A novel insight on an ancient aromatic plant: The rosemary (Rosmarinus officinalis L.). Trends Food Sci. Technol. 2015, 45, 355–368. [Google Scholar] [CrossRef]
- Zeng, J.; Ren, X.; Zhu, S.; Gao, Y. Fabrication and characterization of an economical active packaging film based on chitosan incorporated with pomegranate peel. Int. J. Biol. Macromol. 2021, 192, 1160–1168. [Google Scholar] [CrossRef] [PubMed]
- Kumari, M.; Mahajan, H.; Joshi, R.; Gupta, M. Development and structural characterization of edible films for improving fruit quality. Food Packag. Shelf Life 2017, 12, 42–50. [Google Scholar] [CrossRef]
- Yuan, G.; Lv, H.; Yang, B.; Chen, X.; Sun, H. Physical Properties, Antioxidant and Antimicrobial Activity of Chitosan Films Containing Carvacrol and Pomegranate Peel Extract. Molecules 2015, 20, 11034–11045. [Google Scholar] [CrossRef] [PubMed]
- Ali, A.; Chen, Y.; Liu, H.; Yu, L.; Baloch, Z.; Khalid, S.; Zhu, J.; Chen, L. Starch-based antimicrobial films functionalized by pomegranate peel. Int. J. Biol. Macromol. 2018, 129, 1120–1126. [Google Scholar] [CrossRef] [PubMed]
- Harini, K.; Chandra Mohan, C.; Ramya, K.; Karthikeyan, S.; Sukumar, M. Effect of Punica granatum peel extracts on antimicrobial properties in Walnut shell cellulose reinforced Bio-thermoplastic starch films from cashew nut shells. Carbohydr. Polym. 2018, 184, 231–242. [Google Scholar] [CrossRef] [PubMed]
- Agustinelli, S.P.; Ciannamea, E.M.; Ruseckaite, R.A.; Martucci, J.F. Migration of red grape extract components and glycerol from soybean protein concentrate active films into food simulants. Food Hydrocoll. 2021, 120, 106955. [Google Scholar] [CrossRef]
- Priyadarshi, R.; Kim, S.-M.; Rhim, J.-W. Carboxymethyl cellulose-based multifunctional film combined with zinc oxide nanoparticles and grape seed extract for the preservation of high-fat meat products. Sustain. Mater. Technol. 2021, 29, e00325. [Google Scholar] [CrossRef]
- Sganzerla, W.G.; da Rosa, C.G.; da Silva, A.P.G.; Ferrareze, J.P.; Azevedo, M.S.; Forster-Carneiro, T.; Nunes, M.R.; de Lima Veeck, A.P. Application in situ of biodegradable films produced with starch, citric pectin and functionalized with feijoa (Acca sellowiana (Berg) Burret) extracts: An effective proposal for food conservation. Int. J. Biol. Macromol. 2021, 189, 544–553. [Google Scholar] [CrossRef]
- Gutiérrez, J.B. Ciencia Bromatológica: Principios Generales de los Alimentos; Ediciones Díaz de Santos: Madrid, Spain, 2000. [Google Scholar]
- Márquez-Ruiz, G.; García-Martínez, M.C.; Holgado, F. Changes and Effects of Dietary Oxidized Lipids in the Gastrointestinal Tract. Lipid Insights 2008, 2, 11–19. [Google Scholar] [CrossRef]
- Mariutti, L.R.B.; Bragagnolo, N. Influence of salt on lipid oxidation in meat and seafood products: A review. Food Res. Int. 2017, 94, 90–100. [Google Scholar] [CrossRef]
- Andrade, M.A.; Barbosa, C.H.; Souza, V.G.L.; Coelhoso, I.M.; Reboleira, J.; Bernardino, S.; Ganhão, R.; Mendes, S.; Fernando, A.L.; Vilarinho, F.; et al. Novel Active Food Packaging Films Based on Whey Protein Incorporated with Seaweed Extract: Development, Characterization, and Application in Fresh Poultry Meat. Coatings 2021, 11, 229. [Google Scholar] [CrossRef]
- Andrade, M.A.; Ribeiro-Santos, R.; Guerra, M.; Sanches-Silva, A. Evaluation of the Oxidative Status of Salami Packaged with an Active Whey Protein Film. Foods 2019, 8, 387. [Google Scholar] [CrossRef] [PubMed]
- Castro, F.V.R.; Andrade, M.A.; Sanches Silva, A.; Vaz, M.F.; Vilarinho, F. The Contribution of a Whey Protein Film Incorporated with Green Tea Extract to Minimize the Lipid Oxidation of Salmon (Salmo salar L.). Foods 2019, 8, 327. [Google Scholar] [CrossRef]
- Vilarinho, F.; Andrade, M.; Buonocore, G.G.; Stanzione, M.; Vaz, M.F.; Sanches Silva, A. Monitoring lipid oxidation in a processed meat product packaged with nanocomposite poly (Lactic acid) film. Eur. Polym. J. 2018, 98, 362–367. [Google Scholar] [CrossRef]
- Brody, A.L.; Strupinsky, E.R.; Kline, L.R. Ative Packaging for Food Applications; CRC Press: Boca Raton, FL, USA, 2001. [Google Scholar]
- Silva, A.S.; Freire, J.M.C.; Franz, R.; Losada, P.P. Mass transport studies of model migrants within dry foodstuffs. J. Cereal Sci. 2008, 48, 662–669. [Google Scholar] [CrossRef]
- Umaraw, P.; Munekata, P.E.S.; Verma, A.K.; Barba, F.J.; Singh, V.P.; Kumar, P.; Lorenzo, J.M. Edible films/coating with tailored properties for active packaging of meat, fish and derived products. Trends Food Sci. Technol. 2020, 98, 10–24. [Google Scholar] [CrossRef]
- Moure, A.; Franco, D.; Sineiro, J.; Domínguez, H.; Núñez, M.J.; Lema, J.M. Antioxidant activity of extracts from Gevuina avellana and Rosa rubiginosa defatted seeds. Food Res. Int. 2001, 34, 103–109. [Google Scholar] [CrossRef]
- Erkan, N.; Ayranci, G.; Ayranci, E. Antioxidant activities of rosemary (Rosmarinus officinalis L.) extract, blackseed (Nigella sativa L.) Essential oil, Carnosic acid, Rosmarinic acid and Sesamol. Food Chem. 2008, 110, 76–82. [Google Scholar] [CrossRef]
- Yoo, K.M.; Lee, C.H.; Lee, H.; Moon, B.; Lee, C.Y. Relative antioxidant and cytoprotective activities of common herbs. Food Chem. 2008, 106, 929–936. [Google Scholar] [CrossRef]
- Martins, P.C.; Latorres, J.M.; Martins, V.G.; Machado, A.V. Effect of starch nanocrystals addition on the physicochemical, thermal, and optical properties of low-density polyethylene (LDPE) films. Polym. Eng. Sci. 2022, 62, 1786–1796. [Google Scholar] [CrossRef]
- López-de-Dicastillo, C.; Gómez-Estaca, J.; Catalá, R.; Gavara, R.; Hernández-Muñoz, P. Active antioxidant packaging films: Development and effect on lipid stability of brined sardines. Food Chem. 2012, 131, 1376–1384. [Google Scholar] [CrossRef]
- ISO No. 22196; Measurement of Antibacterial Activity on Plastics and Other Non-Porous Surfaces. International Organization for Standardization: Geneva, Switzerland. Available online: https://www.iso.org/standard/54431.html (accessed on 1 April 2022).
- Rosmini, M.R.; Perlo, F.; Pérez-Alvarez, J.A.; Pagán-Moreno, M.J.; Gago-Gago, A.; López-Santoveña, F.; Aranda-Catalá, V. TBA test by an extractive method applied to ‘paté’. Meat Sci. 1996, 42, 103–110. [Google Scholar] [CrossRef] [PubMed]
- Shantha, N.C.; Decker, E.A. Rapid, Sensitive, Iron-Based Spectrophotometric Methods for Determination of Peroxide Values of Food Lipids. J. AOAC Int. 1994, 77, 421–424. [Google Scholar] [CrossRef] [PubMed]
- BS No. 684-2.24-1989; British Standard Method. Methods of Analysis of Fats and Fatty Oils—Determination of Anisidine Value. SAI Global: Sydney, Australia, 1989. Available online: https://infostore.saiglobal.com/en-us/standards/bs-684-2-24-1989-1989-295559_saig_bsi_bsi_685415/ (accessed on 1 April 2022).
- Rashid, R.; Wani, S.M.; Manzoor, S.; Masoodi, F.A.; Altaf, A. Nanoencapsulation of pomegranate peel extract using maltodextrin and whey protein isolate. Characterisation, release behaviour and antioxidant potential during simulated invitro digestion. Food Biosci. 2022, 50, 102135. [Google Scholar] [CrossRef]
- Selahvarzi, A.; Ramezan, Y.; Sanjabi, M.R.; Namdar, B.; Akbarmivehie, M.; Mirsaeedghazi, H.; Azarikia, F. Optimization of ultrasonic-assisted extraction of phenolic compounds from pomegranate and orange peels and their antioxidant activity in a functional drink. Food Biosci. 2022, 49, 101918. [Google Scholar] [CrossRef]
- El-Hadary, A.E.; Taha, M. Pomegranate peel methanolic-extract improves the shelf-life of edible-oils under accelerated oxidation conditions. Food Sci. Nutr. 2020, 8, 1798–1811. [Google Scholar] [CrossRef]
- Zago, G.R.; Gottardo, F.M.; Bilibio, D.; Freitas, C.P.; Bertol, C.D.; Dickel, E.L.; dos Santos, L.R. Pomegranate (Punica granatum L.) peel lyophilized extract delays lipid oxidation in tuscan sausages. Ciência Rural 2020, 50. [Google Scholar] [CrossRef]
- Xu, J.; Cao, K.; Liu, X.; Zhao, L.; Feng, Z.; Liu, J. Punicalagin regulates signaling pathways in inflammation-associated chronic diseases. Antioxidants 2022, 11, 29. [Google Scholar] [CrossRef]
- Yuniarto, K.; Purwanto, Y.A.; Purwanto, S.; Welt, B.A.; Purwadaria, H.K.; Sunarti, T.C. Infrared and Raman studies on polylactide acid and polyethylene glycol-400 blend. AIP Conf. Proc. 2016, 1725, 020101. [Google Scholar] [CrossRef]
- Bodbodak, S.; Shahabi, N.; Mohammadi, M.; Ghorbani, M.; Pezeshki, A. Development of a Novel Antimicrobial Electrospun Nanofiber Based on Polylactic Acid/Hydroxypropyl Methylcellulose Containing Pomegranate Peel Extract for Active Food Packaging. Food Bioprocess Technol. 2021, 14, 2260–2272. [Google Scholar] [CrossRef]
- Miletić, A.; Pavlić, B.; Ristić, I.; Zeković, Z.; Pilić, B. Encapsulation of Fatty Oils into Electrospun Nanofibers for Cosmetic Products with Antioxidant Activity. Appl. Sci. 2019, 9, 2955. [Google Scholar] [CrossRef]
- Dai, L.; Li, R.; Liang, Y.; Liu, Y.; Zhang, W.; Shi, S. Development of Pomegranate Peel Extract and Nano ZnO Co-Reinforced Polylactic Acid Film for Active Food Packaging. Membranes 2022, 12, 1108. [Google Scholar] [CrossRef] [PubMed]
- Khakestani, M.; Jafari, S.H.; Zahedi, P.; Bagheri, R.; Hajiaghaee, R. Physical, morphological, and biological studies on PLA/nHA composite nanofibrous webs containing E quisetum arvense herbal extract for bone tissue engineering. J. Appl. Polym. Sci. 2017, 134, 45343. [Google Scholar] [CrossRef]
- Venusova, E.; Kolesarova, A.; Horky, P.; Slama, P. Physiological and immune functions of punicalagin. Nutrients 2021, 13, 2150. [Google Scholar] [CrossRef] [PubMed]
- Shivashankara, A.R.; Venkatesh, S.; Bhat, H.P.; Palatty, P.L.; Baliga, M.S. Can Phytochemicals be Effective in Preventing Ethanol-Induced Hepatotoxicity in the Geriatric Population? An Evidence-Based Revisit. In Foods and Dietary Supplements in the Prevention and Treatment of Disease in Older Adults; Elsevier: Amsterdam, The Netherlands, 2015; pp. 163–170. [Google Scholar]
- Baliga, M.S.; Shivashankara, A.R.; Venkatesh, S.; Bhat, H.P.; Palatty, P.L.; Bhandari, G.; Rao, S. Phytochemicals in the Prevention of Ethanol-Induced Hepatotoxicity. In Dietary Interventions in Liver Disease; Elsevier: Amsterdam, The Netherlands, 2019; pp. 79–89. [Google Scholar]
- European Commission Commission Regulation (EU) No 10/2011. Off. J. Eur. Union 2011, L12, 1–89.
- Alexandre, E.M.C.; Silva, S.; Santos, S.A.O.; Silvestre, A.J.D.; Duarte, M.F.; Saraiva, J.A.; Pintado, M. Antimicrobial activity of pomegranate peel extracts performed by high pressure and enzymatic assisted extraction. Food Res. Int. 2019, 115, 167–176. [Google Scholar] [CrossRef] [PubMed]
- Panichayupakaranant, P.; Tewtrakul, S.; Yuenyongsawad, S. Antibacterial, anti-inflammatory and anti-allergic activities of standardised pomegranate rind extract. Food Chem. 2010, 123, 400–403. [Google Scholar] [CrossRef]
- Martínez, L.; Castillo, J.; Ros, G.; Nieto, G. Antioxidant and Antimicrobial Activity of Rosemary, Pomegranate and Olive Extracts in Fish Patties. Antioxidants 2019, 8, 86. [Google Scholar] [CrossRef]
- Giannelli, M.; Lacivita, V.; Posati, T.; Aluigi, A.; Conte, A.; Zamboni, R.; Del Nobile, M.A. Silk Fibroin and Pomegranate By-Products to Develop Sustainable Active Pad for Food Packaging Applications. Foods 2021, 10, 2921. [Google Scholar] [CrossRef]
- Chen, J.; Liao, C.; Ouyang, X.; Kahramanoğlu, I.; Gan, Y.; Li, M. Antimicrobial Activity of Pomegranate Peel and Its Applications on Food Preservation. J. Food Qual. 2020, 2020, 1–8. [Google Scholar] [CrossRef]
- Yuan, G.; Lv, H.; Tang, W.; Zhang, X.; Sun, H. Effect of chitosan coating combined with pomegranate peel extract on the quality of Pacific white shrimp during iced storage. Food Control 2016, 59, 818–823. [Google Scholar] [CrossRef]
- Licciardello, F.; Kharchoufi, S.; Muratore, G.; Restuccia, C. Effect of edible coating combined with pomegranate peel extract on the quality maintenance of white shrimps (Parapenaeus longirostris) during refrigerated storage. Food Packag. Shelf Life 2018, 17, 114–119. [Google Scholar] [CrossRef]
Disclaimer/Publisher’s Note: The statements, opinions and data contained in all publications are solely those of the individual author(s) and contributor(s) and not of MDPI and/or the editor(s). MDPI and/or the editor(s) disclaim responsibility for any injury to people or property resulting from any ideas, methods, instructions or products referred to in the content. |
© 2023 by the authors. Licensee MDPI, Basel, Switzerland. This article is an open access article distributed under the terms and conditions of the Creative Commons Attribution (CC BY) license (https://creativecommons.org/licenses/by/4.0/).